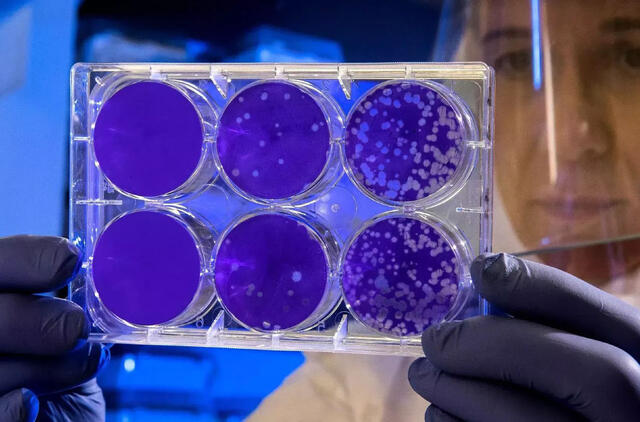

Pavojus atėjo, iš kur nelaukta: superbakterijų rastos netikėtoje vietoje
Pasak „New Atlas“, mokslininkai išanalizavo debesų sudėtį prie miegančio Piui de Domo ugnikalnio centrinėje Prancūzijoje ir per dvejus metus paėmė 12 mėginių.
Kaip paaiškėjo, kiekviename vandens mililitre galima rasti vidutiniškai 8 tūkst. bakterijų, kuriose yra apie 20,8 tūkst. antibiotikams atsparių genų.
Mokslininkai pastebėjo, kad debesyse, kurie prie kalno atslinko per vandenyną, buvo kitokių atsparių bakterijų atmainų nei tuose debesyse, kurie slinko tik virš sausumos. Pastaruosiuose aptikta daugiau bakterijų, kurios buvo atsparios gyvuliams gydyti naudojamiems antibiotikams.
Nors jau seniai žinoma, kad atmosfera yra tranzitinis bakterijų plitimo kelias, mokslininkai nustebo, kad debesyse sugebėjo rasti tokio pat lygio genų kaip ir paviršiuje.
Pasak tyrimo autorių, pagrindinis šių genų šaltinis, atrodo, yra antibiotikų naudojimas gyvulininkystės sektoriuje.
Ligų kontrolės ir prevencijos centrų duomenimis, dėl antibiotikams atsparių bakterijų ar grybelių pasaulyje kasmet miršta apie 1,27 mln. žmonių, su tokiomis bakterijomis ar grybeliais kovoti kasmet darosi vis sunkiau.

































Rašyti komentarą